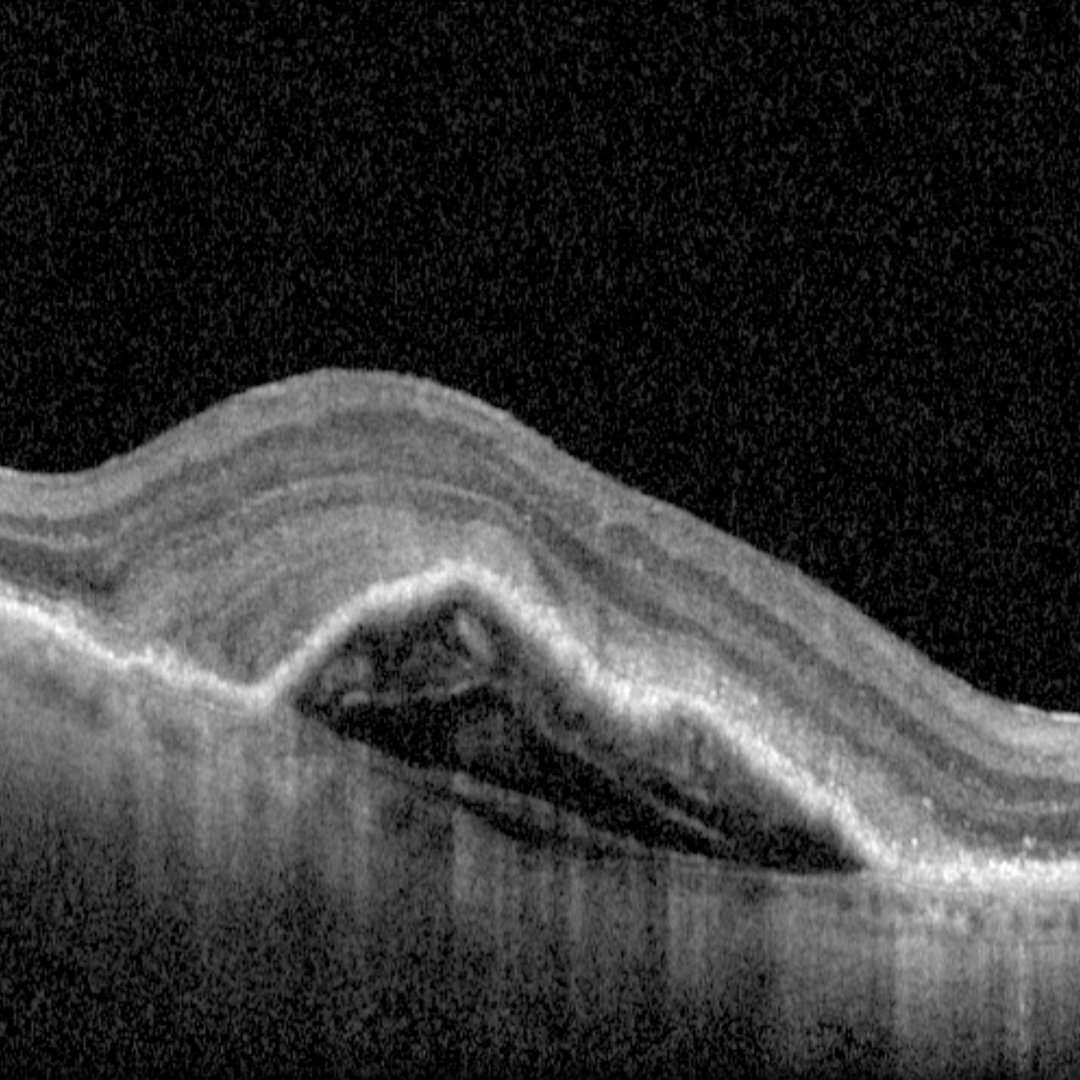

Overview
The term Pigment Epithelial Detachment (PED) refers to separation of the RPE from the underlying Bruch’s membrane and is best appreciated on OCT. There are several key types of PED – serous, fibrovascular and drusenoid, however a PED may be considered “mixed” if there is more than one of these components present.
A serous PED is a localised, dome-shaped RPE elevation showing internal hypo-reflectivity in the space between the RPE and Bruch’s membrane. A serous PED does not change the reflectivity of underlying structures.
Drusenoid PEDs are smooth areas of RPE elevation with typically homogenous internal reflectivity, but can have variable internal reflection. Studies vary on the size definition for defining Drusenoid PEDs with the AREDS study using at least 350 microns in the narrowest diameter as a criterion.
Fibrovascular PEDs again show an elevation of the RPE however these have heterogenous internal reflectivity. This means that there are areas of both hyper- and hypo-refelctivity within the area between the RPE and Bruch’s membrane. Posterior shadowing is a feature of fibrovascular PEDs, reducing the reflectivity of deeper structures.
The term FIPED (flat irregular PED) refers to a shallow separation of the RPE and Bruch’s membrane which can be associated with type 1 choroidal neovascularisation.
Types of PED
References
Guo, J. Tang, W. Xu,S. Liu,W. Xu, G. (2020) OCTA evaluation of treatment-naïve flat irregular PED (FIPED)-associated CNV in chronic central serous chorioretinopathy before and after half-dose PDT Eye 12-15
Nkrumah, G. Paez-Escamilla, M. Singh, SR, Rasheed, MA, Maltsev, D. Guduru, A. Chhablani, J. (2020) Ther Adv Ophthalmol Vol. 12: 1–14


